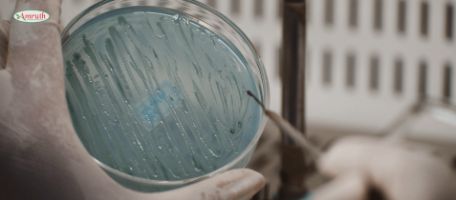
microbial-1

SOIL AND WATER SAMPLING FACILITY
- The factory is blessed with modern facilities like, biochemistry, biotechnology laboratories & soil science research and development wing.
- State of art soil testing laboratory is at the helm of our activity and is instrumental in providing soil health cards to organic farmers.
- Critical analysis of pH, Ec, % N,P, K, Ca, S, Mg, Mn, B, Fe, & Zn contents in soil have provided insight into our product development and soil health care.
- Contaminant & impurity analysis of irrigable and sewage waters has led to the correction in the pH value by remedies.